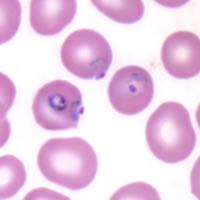

The College of Remote and Offshore Medicine Foundation is an academic not-for-profit organisation for healthcare professionals working in the remote, offshore, military and security industries.



The College was founded in 2014 and is governed by a voluntary Academic Board supported by a faculty of medical professionals from four continents. The College is registered with the National Commission for Further and Higher Education of Malta and is a degree granting educational institution.
CoROM focuses on the improvement of medical training and the practice of healthcare for those working in remote, austere and resource-poor environments.



We provide clinical research and academic training in Tropical Medicine for medical professionals located worldwide.
CoROM provides the Tropical Medicine module for the NATO Special Operations Combat Medic (NSOCM) course at the International Special Training Centre in Pfullendorf, Germany.
The tyranny of distance requires that medical professionals working in Africa, Asia and the Middle East must have the ability to provide best practice medicine for extended periods of time.
CoROM focuses on the practice of medicine with limited resources and the ability to improvise whilst providing excellent medical care.
The ability to provide care for critically ill casualties must be available regardless of location and resources. CoROM provides Critical Care Transport curriculum and expands into the provision of critical care in less than ideal environments.



The College has been busy over this summer break. We have been redesigning the two-year Higher Diploma Remote Paramedic Practice into a full three-year Bachelor of Science. The programme has been submitted to the Malta Department of Education for accreditation. We have 22 students enrolled for the Autumn Semester. They were busy working on the completely revamped online eLearning platform. We are already taking names of people interested in starting their BSc for the Spring Semester in January. Additionally, we have submitted our MSc in Prehospital Critical Care for accreditation and hope to start enrolling students for the Spring Semester starting in January.

The 2nd edition field guide has sold almost 1,000 copies so far. We have 100 copies purchased by one of the Security Force Assistance Brigades which are part of the support units for each of the Special Forces Groups. Additionally, every medic in the Irish Army Ranger Wing has a copy. We are currently working on the updated CoROM application which will have an offline version of the field guide available for your smartphones.

The College is not letting the pandemic slow us down. We have three faculty who are speaking at the Special Operations Medical Association’s conference starting on 15 September. We speak at every SOMSA conference and have our table in their exhibition hall. This year, they have moved this into a virtual conference. Dr de Mello will be speaking on the treatment of burns during Prolonged Field Care. Jason Jarvis will give his normal malaria lecture as well as the top five infectious diseases. I will give my usual SOMSA lecture on tactical medicine review where I discuss how to pass the Tactical Paramedic board certification.

Quite a few CoROM faculty attended the virtual Wilderness Medical Society conference in July. It was nice for me to see at least one of our graduates in every lecture that I attended. CoROM continues to be the largest provider of FAWM credits outside of the United States. We would like to congratulate our faculty and graduates who earned their Fellowship of the Academic of Wilderness Medicine this summer. One of our Founders, Dr. Andrew Grech also earned his FAWM this summer.
The College continues to move from strength to strength. Join us as we grow.

Screenshots of CoROM’s online CPD courses








Pharmacology for the Remote Medic



Remote Medical Life Support
TTEMS online
Aeromedical Retrieval Medicine for Extreme Altitudes (ARMEA)






The College was invited back to speak at the Special Operations Medical Associations Scientific Assembly. We have been presenters for each of the SOMSA conferences for the past four years now. Due to the pandemic, this years conference went virtual. Here are the topics that our faculty presented.


For more information about training with CoROM, please visit corom.org. Please address newsletter correspondence to editor@corom.org.




CoROM alumnus Michael Klopper earned his National Registry Paramedic from the USA and works in South Africa in search and rescue units as well as focusing on paramedic education.
 Michael Klopper NRP Paramedic
Michael Klopper NRP Paramedic
My interest in remote and wilderness medicine came from working with Mountain Search and Rescue in South Africa. I had been with the MSAR team since 2009 and am part of the heli, technical and medical team. In 2014 I became a Fellow of the Academy of Wilderness Medicine and I wanted to continue to increase my knowledge of all things remote medicine. Having met Aebhric through the FAWM program, I helped CoROM (then Merit Training) set up clinical sites in South Africa. In 2015 I travelled to Malta to help out with the remote paramedics course and to learn as much as I could from the instructors and students – I left Malta as twice the remote medic when I arrived in terms of the knowledge and practical experience gained.
Since 2015, I became a US Nationally Registered Paramedic and now work primarily in education. With a strong background in information technology, I also develop apps and other systems to assist paramedic students in their studies. I still work with MSAR on more complex incidents and training. I also support local EMS and urban rescue in South Africa however I can.






Greeting all,
Jason Jarvis 18D BSc NREMT-P CoROM TropMed LeadDespite the restrictions that the SARS-CoV-2 pandemic has forced upon all of us, my work in the United States as a freelance medical educator has ballooned enormously. In addition, I am entering my second year at the London School of Hygiene and Tropical Medicine as a master’s student in Infectious Diseases.
To do justice to my role as CoROM’s Tropical Medicine Lead - while engaging in my own studies and freelance work - I will regrettably be stepping down from the position as editor for The Compass.



It has been an exciting and rewarding two years since the inception of The Compass. I have enjoyed all the articles written by CoROM’s faculty and former students, as well as the challenges of sifting through PubMed for austere medicine articles worth highlighting.
Editing The Compass is no easy task, and I am grateful to Aebhric O’Kelly for taking on this duty. I intend to continue writing the Trends in Traumatology piece, the book review, and the Test Yourself section.
Many thanks to all the readers of the Compass, I hope that I have a chance to work with all of you in the future.
Jason Jarvis Seattle, Washington Jason teaching microscopes in the NSOCM classroomJessica comes from a Sales & Marketing background, having most recently worked with Eventbrite ticketing provider. Her experience comes from being part of as well as managing high-performing sales teams, from agent level through to managing Revenue Enablement across multiple European teams. She’s worked in e-commerce with companies like PayPal and UberEats, as well as Irish start-up companies and multinational organisations.
I took a break from working after being made redundant in March of this year, time off to re-evaluate what I wanted to do. After years of high-pressure, target-driven roles it was much needed!


I was looking for a change of direction away from commercial, corporate roles. The vision of the College - to provide the best possible education the field can offer - is matched by a real passion for continuous improvement behind the scenes. My future husband is a trained Remote Paramedic so I’ve seen first hand the amount of time and dedication it takes to qualify and work in those fields, and that the learning never stops.

Whether it’s building apps, improving channels for student communication or ensuring the website is as user friendly as possible, the team is dedicated to continuously levelling up the learning process just as much as the content itself and that’s a goal I can get behind.



A lot of learning comes down to personal preference. I don’t think you can beat a pen and paper for sheer simplicity for studying - something about writing cements information in my brain better than any other method.
That said, I’m a total geek when it comes to ergonomics. You can create a digital space that’s super efficient, allowing you access information from multiple sources. I like Feedly as an RSS reader for categorizing content from multiple sources, which can then be browsed really efficiently. IFTTT is an amazing tool - it allows you to create basic ‘rules’ for situations where “If That, Then This” happens automatically.
I’m also really excited that the College has been granted access to Google Suite for Education. I’m very much looking forward to implementing this - especially with so much forced COVID distance - to connect and communicate with our faculty and students.
Building on the current system of implementation and improvement, I can see the student experience being nonpareil with access to apps & education designed for those in active work. Hopefully all thought of ‘pandemic’ will be a distant memory and in-person training and placement will have grown across new countries. Year 3 will be fully accredited so I’m also looking forward to seeing where Remote Paramedic Practitioner graduates end up!


Mike Shertz, 18D/MD, DTM&H is a former U.S. Army Special Forces medic, board certified Emergency Physician who also has a diploma in Tropical Medicine and Hygiene. He works in Portland, Oregon but travels in the developing world whenever possible. He also offers TECC/TCCC courses online at www.crisis-medicine.com.
Dr. Michael Shertz 18D/MD, DTM&H CoROM Faculty
A 53-year-old male oil executive presents to the Emergency Department for one week of subjective fever, chills, body aches, and fatigue. His symptoms began three days after returning from a business trip to Chad. He travels there several times per year and stays one month on each trip. He does not use malaria chemoprophylaxis when he travels.

He is febrile to 38.2C, mildly tachycardic at 110, BP 110 / 70, respiratory rate 22, and O2 saturations 98%. He has very mild scleral icterus.
Short (not so short) differential diagnosis for fever in a returning traveller from Chad: Malaria, Dengue / Chikungunya, Rickettsia infections (African Tick Bite Fever), HIV seroconversion syndrome, Typhoid, Leptospirosis, African trypanosomiasis, various haemorrhagic fevers, and systemic fungal infections.
Routine laboratory testing showed mild anaemia, slight thrombocytopenia, and slight elevation of his total bilirubin. His malaria thin and thick smears were positive for P. falciparum at 1% parasitaemia.
He was treated with Artemether and lumefantrine (Co-Artem) for three days. His follow-up thin and thick films were negative on day three.
When considering fever in a returning traveller the first question that must be asked is: Is this malaria?
Malaria remains the most clinically important travel related febrile illness as it can rapidly cause death. In a study of 47,173 ill travellers seeking medical care upon return home, 23.3% reported fever as their chief complaint. Malaria was diagnosed in 29% of those with fever and disproportionally those visiting Africa.1
If the traveller does have malaria, the second and subsequent questions become relevant. Is this Plasmodium falciparum?
Of the five malaria types that infect humans, P. falciparum is generally viewed as the only fatal malaria. Plasmodium falciparum has been responsible for one quarter of infectious travel related deaths.1 Though P. knowlesi is now also known to cause fatalities, its case fatality rate is only 2.5 per 1000.2 I am not aware of any traveller related deaths. P. falciparum has shown an 11% fatality rate in travellers with severe malaria returning to Europe.3,4 Plasmodium vivax can cause severe and complicated malaria with subsequent death, but that is generally uncommon.

- Dr. Mike Shertz

“Crisis Medicine trains students to quickly identify and treat immediately life-threatening injuries during a highrisk environment and avoid unnecessary loss of life”
The degree of parasitaemia represents the percentage of red blood cells infected with malaria. One of the ways P. falciparum causes more severe disease (compared to the other malarias) is through higher levels of parasitaemia. More red cells are infected leading to more red cell destruction and more micro circular obstruction. Though the WHO uses over 5% parasitaemia as the break point for hyperparasitaemia, in non-immune / travellers’, patients with 2% parasitaemia can get very ill.
Is there evidence of severe or complicated malaria?
The usually accepted definition is basically end organ dysfunction caused by P. falciparum. Almost any organ can be involved. Cerebral malaria involves brain dysfunction, altered mental status, and seizures. Respiratory distress can occur secondary to metabolic acidosis, anaemia, and pulmonary oedema. Jaundice, renal impairment, abnormal bleeding, can also occur. The list is long.
And finally, can they take PO or oral medication?
In general malaria is treated with two drugs. One that rapidly kills the parasite in the red blood cells but doesn’t persist in the body and another which remains in the system much longer, providing an ongoing antiplasmodial affect. The rapid agent provides an immediate reduction in parasitaemia but doesn’t last long which can encourage drug resistance. The slower killing drug mops up the remaining parasites leading to the resolution of the infection. Currently artemether and lumefantrine is considered one of the best oral agents for treatment. The artemether provides rapid killing (halflife 2 hours) and lumefantrine (half-life 2-3 days) the slower and more prolonged eradication.

Even in severe and complicated malaria, patients are typically converted from IV / IM treatment to oral after 24 hours, if vomiting isn’t an issue.
Plasmodium falciparum parasites in red blood cells, not the patient’s actual smear.
To the right is Jason Jarvis using the Newton field microscope to assess a blood smear.

References
1 Geosentinel Surveillance of illness in returned Travelers, 2007 Ann Intern Med. 2013 March 19; 158(6): 456-468

2 Deaths from Plasmodium knowlesi Malaria: Case Series and Systematic Review. Rajahram GS, Cooper DJ, et all. Clin Infect Dis. 2019, Nov 15; 69(10): 1703–1711.
3 The Clinical Spectrum of Severe Imported Falciparum Malaria in the Intensive Care Unit: Report of 188 Cases in Adults. Bruneel F, Hocquelox L, et all. Am J Respir Crit Care Med. 2003 Mar 1;167(5):684-9.




Dr Francis Sakita is head of the Emergency Department at the Kilimanjaro Christian Medical Centre and a lecturer at the Kilimanjaro Christian University College in Moshi, Tanzania.
 Dr. Francis Sakita MD MMed
Dr. Francis Sakita MD MMed
Greetings from the land of Kilimanjaro
It is my great hope that you are fine wherever you are. This year has been special due to the ongoing COVID 19 pandemic which continues to hit countries all over the world. Amid this pandemic, we had a case which was of a 25 years old man, a Tanzanite miner who has been working for the past three years using only cloth mask for protection from dust. He presented with history of sudden onset of difficulty in breathing following an incident of accidentally touching electrical wires with a bare hand (thumb, index and middle fingers got contact) while climbing out of the mine pit three days prior to admission. The difficulty in breathing was associated with a productive cough which was blood stained and minimal in amount. The patient denied history of being thrown after electrocution or losing consciousness or convulsing or developing fever before or after the incident. Upon arrival at the ED, the primary survey was remarkable for dyspnoea and bilateral coarse crepitations more on the right side. His initial vital signs were BP-133/54 mmHg, PR- 92 beats/min, RR- 24 cycles/min, SPO2- 86% in RA to 98% 10 litres using simple facemask, Temp -36.2*C. The rest of the secondary survey was unremarkable. A diagnosis of low voltage electrical lung injury was suspected. Also since it is COVID 19 era, the patient was treated as a COVID 19 suspect due to the presenting features of DIB and desaturation. A differential of acute silicosis was sought and confirmed by the Chest CT scan later. He was isolated and the nasopharyngeal swab test for COVID 19 was taken. Initial blood works revealed neutrophilia of 86% other parameters were normal, ESR- normal, Electrolytes were normal, Creatinine Kinase was elevated (11.4 U/L), serum creatinine was normal and serology for HIV was negative. Other investigations were ECG which showed sinus rhythm and POCUS showed diffuse B-lines more on right side, normal cardiac contractility.
Initial management at the ED, the patient was given IV fluids, IV Ceftriaxone 2g stat, IV hydrocortisone 200mg stat and IV tranexamic acid 1g stat. The patient was admitted in the Isolation unit and stayed for three days where he improved remarkably and was discharged home with oral medications. Unfortunately, we could not get hold of the patient after discharge for a follow up chest X-ray. His COVID 19 test was Negative.
This was one of the rare cases presenting to the ED at the time where we had a peak of COVID 19 cases. This was a challenging case as far as disposition was concerned. Even though it was a sudden onset, no documented history of fever and prior to the incident the patient was apparently well. The ED team had to take all the standard precaution measures against COVID 19 not to expose other patients and staff in the general ward by sending the patient to the Isolation ward.
Credits to Dr. Abedi Zakayo, amazing ED doctor who received, evaluated and treated this case. He penned down the first draft of this case.
Our sincere condolences to those who lost their loved ones from COVID 19. We pray for a Godspeed recovery for those who are sick or will be sick and comfort for those who lost their loved ones. Until next edition, stay safe, stay well.

Hemostatic agents – materials applied externally to severely bleeding wounds – have run the gamut over the past 17 years from powders to gauzes to syringes. Probably the biggest misconception I encounter from students in the various trauma courses I teach is that all hemostatic agents “get hot” when in contact with blood (or sweat). As with many misconceptions, there is a kernel of truth to this. One of the first two hemostatic agents approved for use by the U.S. Department of Defense in 2003 was QuikClot, and this indeed caused a substantial exothermic reaction when in contact with fluids. As one of the firstgeneration hemostatic agents (besides HemCon), QuikClot was adopted by the U.S. Marines and saw plenty of service in conflict zones. Sustained contact with activated QuikClot could cause 2nd-degree burns and there was no shortage of “war stories” that elaborated on that point. Combat Gauze, QuikClot’s successor made by the same company, has enjoyed commercial success, though the persistence of the QuikClot “brand” on the packaging has done little to allay the fear of a heat reaction with blood.
 Jason Jarvis
18D BSc NREMT-P CoROM TropMed Lead
Jason Jarvis
18D BSc NREMT-P CoROM TropMed Lead


Fast-forward to 2020: QuikClot has been dropped by all of the major military services due to the advent of much more user-friendly products such as Combat Gauze, Celox Gauze, Chitogauze Pro, and XStat None of these agents contain the active ingredient found in QuikClot: zeolite. The zeolite used in QuikClot and QuikClot Advanced Clotting Sponge worked by adsorbing water from the blood, leaving behind concentrated clotting factors and the heat byproduct caused by the water shift.




The current Tactical Combat Casualty Care (TCCC) guidelines recommend hemostatic agents which employ either kaolin or chitosan. Kaolin works by “initiating the clotting process by activating factor XII of the clotting cascade.” Chitosan, on the other hand, works by “cross-linking red blood cells to form a mucoadhesive barrier.” In addition to gauze-type hemostatic agents, there is a place in the well-prepared medical practitioner’s arsenal for syringe-injected hemostatic agents. These are ideal for severe bleeds that are not amenable to tourniquet application (i.e., in the junctional zones) with a break in the skin that is less than the diameter of the practitioner’s finger. External bleeding through a small break in the skin is extremely difficult to pack manually without the use of hemostats.





A list of syringe-injected agents – running from smallest nozzle opening to largest is as follows: CeloxApplicator, BallistiClot, and XStat

One of your colleagues at the Mae Tao Clinic in Thailand asks for your assistance interpreting a patient’s 12-lead ECG. What presumptive diagnosis could you make based solely on this 12-lead?

A. Pericarditis
B. Pericardial effusion

C. Pulmonary embolism

D. Severe head trauma

Your clinical supervisor has ordered your patient be infused with lactated ringers at 70 mL/hour. The IV pump is undergoing maintenance and you have 15 drop/mL infusion tubing. At how many drops per minute should you infuse the fluid?



During a rotation through a refugee clinic in Cox’s Bazar in Bangladesh, you overhear a colleague describing their patient’s signs as high fever, widespread arthralgia, some petechial haemorrhage distal to the site the blood pressure was measured, and a generalized rash described as “white islands in a sea of red.” What presumptive diagnosis could you make with this information?
A. Dengue
B. Malaria

C. Silicosis
D. Vitamin E deficiency
Answers will appear in the Winter 2020
Answers to “Test Yourself” from the previous issue:
ECG: C. Mobitz II heart block
Clinical calculation: 1.52mL of sarilumab
Case study: D. Bubonic plague





Medical References (Michael Klopper’s picks)
Gear Watch (Aebhric O’Kelly’s Pick)
Viatom Checkme Pro
The College has a few of these in the classroom. There is the Lite and the Pro versions. The Pro monitors BP, Temp, SPO2 and ECG. The Lite only monitors for ECG and SPO2.
Using these two ECG leads you can easily move them around to get lead I, II, III and the six chest leads.

You can use bluetooth to connect to your phone or tablet and have a decent patient monitor.
As you can see, we always use clingfilm or Saran Wrap to secure the ECG to the patient.
https://www.viatomtech.com/checkme-pro

 Review by Jason Jarvis
Review by Jason Jarvis


SARS-CoV-2 is the latest member of the pantheon of bat related zoonoses such as SARS Ebola, Marburg, Hendra virus, and increase in zoonoses which call their home (or reservoir) bats, it is important to keep some ecological perspective on what is a much
This perspective can be gained with a reading of Alliance’s Living Safely With Bats, a free open to the ins ands outs of coexisting with bats. This guide is available in PDF format in both English and Mandarin at this

The guide is divided six sections which highlight the ecological pros and cons of bats. Just like their bad-press brethren mosquitoes, bats fill a vital ecological niche whose absence would certainly cause both foreseen and unforeseen disastrous effects. Like bees, bats are pollinators; in addition, many bat species are insect eaters.


Using copious illustrations and simple terminology, Living Safely With Bats explains what to do when encountering bats either in one’s home or outdoors, and how dead bats should be handled and disposed of.
It is important that we learn to coexist with the different animals which are responsible for many of the modern emerging infectious diseases. Further human encroachment into their natural habitats and carelessness could very well trigger the next pandemic.









Prolonged field care
Tropical medicine

Extended formulary




Snakes & arthropods
ACLS & ECGs


Paediatric ALS & diseases


OB/Gyn
Dentistry

Ultrasound

Dermatology & STIs
Field laboratory techniques
Environmental medicine
Call-for-evacuation templates

Canine medicine
…and much more!